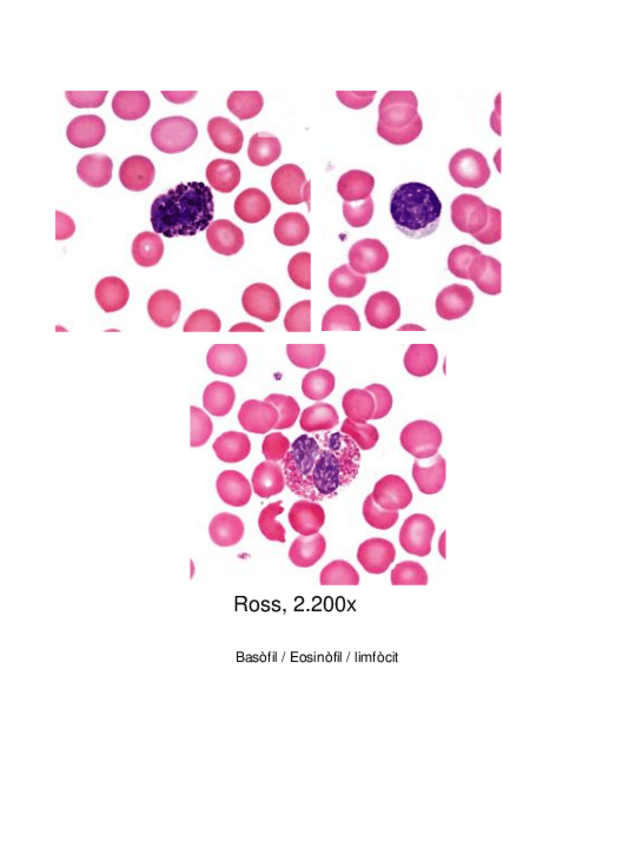

@Iris_aznar
115 Publicaciones
484 Interacciones
1 Seguidores
0 Siguiendo
Lista de publicaciones de Iris_aznar
He publicado nuevos apuntes de 3º Farmacología: Apuntes-farmacologia.pdf
He publicado nuevos apuntes de 3º Patología Vascular: Temario-hasta-tema-5.pdf
He publicado nuevos apuntes de 3º Farmacología: Generalidades-primer-parcial.pdf
He publicado nuevos apuntes de 3º Cáncer i: T1-introduccion-neoplasia.pdf
He publicado nuevos apuntes de 3º Neurociencia Fundamental: Neuroanatomia.pdf
He publicado nuevos apuntes de 2º Ingeniería Genética: Segundo-parcial-Apuntes.pdf
He publicado nuevos apuntes de 2º Ingeniería Genética: EG-apuntes-primer-parcial.pdf
apuntes
-
Resumen Ginecología
He publicado nuevos apuntes de 2º Fisiopatología Humana: Resumen Ginecología
ejercicios
-
Problemas Genética
He publicado nuevos ejercicios de 2º Genética: Problemas Genética
He publicado nuevos apuntes de 1º Biología Molecular: PCR-Polymerase-Chain-Reaction.pdf
apuntes
-
Seminarios
He publicado nuevos apuntes de 1º Histología Humana: Seminarios